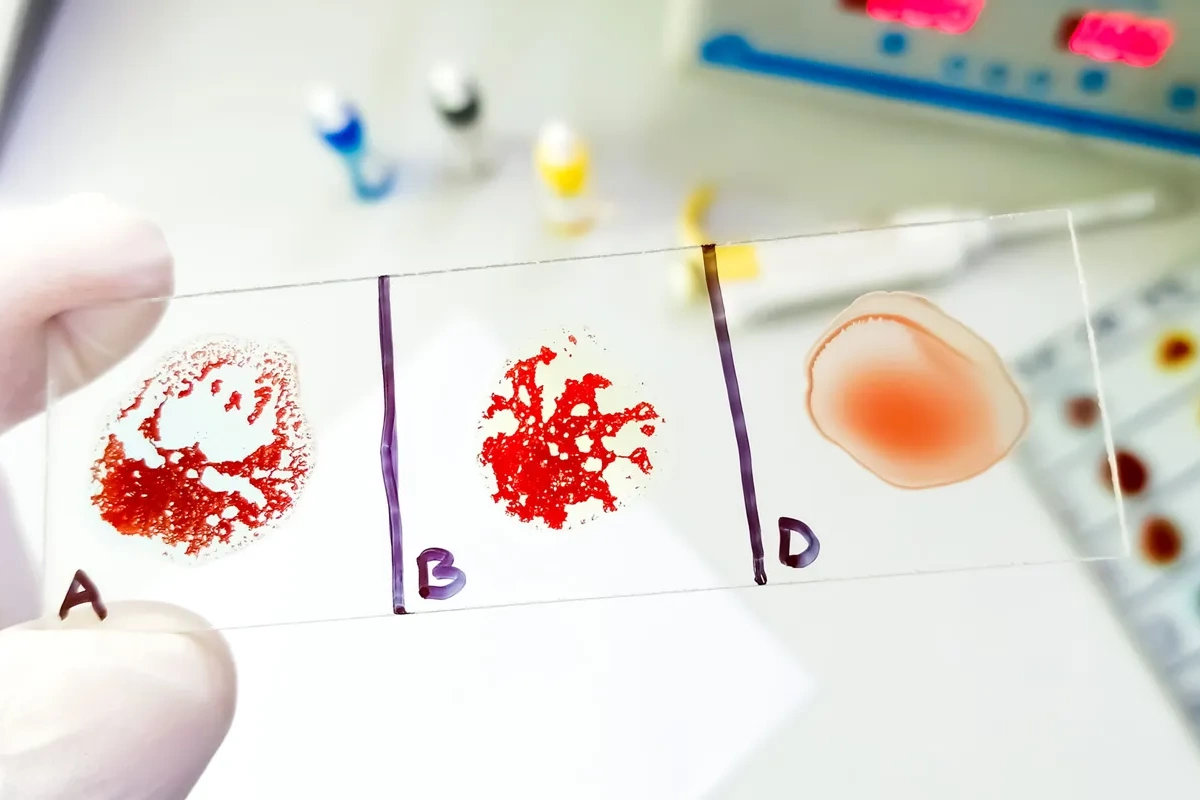
Hansı qan qrupu sağlamlıq baxımından daha üstün sayılır? – Araşdırma

Hansı qan qrupu sağlamlıq baxımından daha üstün sayılır? – Araşdırma
Yeni elmi araşdırmalar qan qrupları ilə bəzi xəstəliklərə meyillilik arasında əlaqə olduğunu göstərir.
BAKU.WS xəbər verir ki, ən çox istifadə olunan ABO sistemi qan qruplarını eritrositlərin səthindəki antigenlərə görə müəyyən edir. Bu sistemə əsasən I (O), II (A), III (B) və IV (AB) qrupları fərqləndirilir.
Araşdırmalar göstərir ki, I (O) qan qrupu müəyyən üstünlüklərlə seçilə bilər. Belə ki, bu qrupa sahib insanlarda tromboz riski digər qruplarla müqayisədə daha aşağıdır.
Mütəxəssislər bildirir ki, bu fərq qanda dövr edən bəzi zülalların miqdarı ilə bağlıdır.
Bununla yanaşı, II (A), III (B) və IV (AB) qan qruplarında ürək-damar xəstəlikləri və qan laxtalanması riskinin nisbətən yüksək olduğu qeyd olunur.
Elmi müşahidələr IV (AB) qan qrupuna malik şəxslərdə yaş artdıqca yaddaş problemləri və koqnitiv zəifləmə ehtimalının daha çox ola biləcəyini də göstərir.
Digər tədqiqatlarda isə II (A) və IV (AB) qan qruplarının Helicobacter pylori infeksiyasına daha həssas olduğu və bunun qastrit və mədə xəstəlikləri riskini artırdığı vurğulanır.
Bəzi nəticələrə görə, I (O) qan qrupuna sahib şəxslərdə COVID-19 infeksiyasının daha ağır keçmə ehtimalı nisbətən aşağıdır.
Bununla belə, mütəxəssislər qeyd edir ki, qan qrupu sağlamlığa təsir edən amillərdən yalnız biridir. Ümumi həyat tərzi, qidalanma və fiziki aktivlik daha həlledici rol oynayır.
Oxşar xəbərlər
Lənkərandakı Dairəvi qalada bərpa işlərinə başlanılıb
Lənkərandakı Dairəvi qalada bərpa işlərinə başlanılıb. BAKU.WS xəbər verir ki, bu barədə Mədəniyyət Nazirliyi yanında Mədəni İrsin Qorunması, İnkişafı və Bərpas...



 Azərbaycanca
Azərbaycanca  По-русски
По-русски  English
English 







